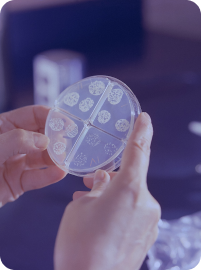

Reproductive Genetics
Preimplantation Genetic Testing for Aneuploidy (PGT-A)
Preimplantation Genetic Testing for Monogenic Disorders (PGT-M)
Preimplantation Genetic Testing for Aneuploidy (PGT-A)
Preimplantation Genetic Testing for Monogenic Disorders (PGT-M)
Clinical Whole Exome Sequencing (cWES)
Preimplantation Genetic Testing for Aneuploidy (PGT-A)
Preimplantation Genetic Testing for Monogenic Disorders (PGT-M)
Clinical Whole Exome Sequencing (cWES)
Search
Latest Insight
Genalive bring you the most current and compelling updates, and insights.